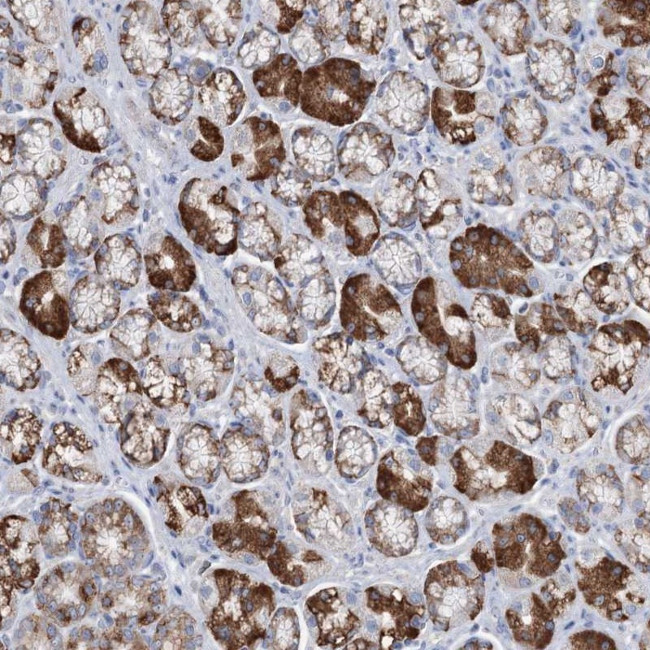
TRIM71 Antibody in Immunohistochemistry (Paraffin) (IHC (P))

Search
Invitrogen
TRIM71 Polyclonal Antibody
{{$productOrderCtrl.translations['antibody.pdp.commerceCard.promotion.promotions']}}
{{$productOrderCtrl.translations['antibody.pdp.commerceCard.promotion.viewpromo']}}
{{$productOrderCtrl.translations['antibody.pdp.commerceCard.promotion.promocode']}}: {{promo.promoCode}} {{promo.promoTitle}} {{promo.promoDescription}}. {{$productOrderCtrl.translations['antibody.pdp.commerceCard.promotion.learnmore']}}
产品信息
PA5-58265
种属反应
宿主/亚型
分类
类型
抗原
偶联物
形式
浓度
规格
纯化类型
保存液
内含物
保存条件
运输条件
RRID
产品详细信息
Immunogen sequence: IKSFGFVSSG AFAPLTKATG DGLKRALQGK VASFTVIGYD HDGEPRLSGG DLMSAVVLGP DGNLFGAEVS DQQNG
Highest antigen sequence identity to the following orthologs: Mouse - 92%, Rat - 92%.
靶标信息
TRIM71 is the mammalian ortholog to the C. elegans heterochronic protein Lin41, a protein that is thought to be important in postembryonic development, and is genetically and biochemically downstream of both Shh and Fgf signaling pathways. Similar to its C. elegans homolog, TRIM71 is a target of the microRNA let-7 and is likely to play a role in mammalian development. Recent experiments have indicated that TRIM71 is an E3 ubiquitin ligase and can interact with the Dicer and the Argonaute proteins Ago1, Ago2, and Ago4. Overexpression and depletion of TRIM71 led to inverse changes in Ago2 protein levels, suggesting TRIM71 can regulate Ago2 turnover. Finally, TRIM71 cooperates with the pluripotency factor Lin-28 in regulating let-7.
仅用于科研。不用于诊断过程。未经明确授权不得转售。
篇参考文献 (0)
生物信息学
蛋白别名: abnormal cell LINeage LIN-41; E3 ubiquitin-protein ligase TRIM71; homolog of C. elegans Lin-41; Protein lin-41 homolog; RBCC protein; RING-type E3 ubiquitin transferase TRIM71; tripartite motif containing 71, E3 ubiquitin protein ligase; Tripartite motif-containing protein 71
基因别名: HYC4; HYDCC1; LIN-41; LIN41; TRIM71
UniProt ID: (Human) Q2Q1W2
Entrez Gene ID: (Human) 131405